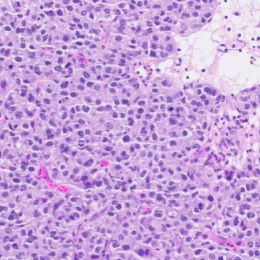

Price | 1784€+ Login to see price |
Organism | |
Product Type | Organoid |
Tissue | |
Disease | Ovarian Cancer |
Drug Test (Organoid Only)
Establishing a process for isolating cytotoxic T cells that can directly attack cancer cells, creating an MHC-TCR
interaction environment, and utilizing MHC I/II blockers to achieve an immune microenvironment in vivo.
Using Immune Cell Co-culture
Establishing a process for isolating cytotoxic T cells that can directly attack cancer cells, creating an MHC-TCR
interaction environment, and utilizing MHC I/II blockers to achieve an immune microenvironment in vivo.
Using Cancer Associate Fibroblast
Establishing a process for isolating cytotoxic T cells that can directly attack cancer cells, creating an MHC-TCR
interaction environment, and utilizing MHC I/II blockers to achieve an immune microenvironment in vivo.

“...However, predicting drug responsiveness has been challenging due to variability between patients. Lambda Biologics’ patient-derived organoids address this issue by reflecting the unique characteristics of individual patients. These organoids allow...

“...However, predicting drug responsiveness has been challenging due to variability between patients. Lambda Biologics’ patient-derived organoids address this issue by reflecting the unique characteristics of individual patients. These organoids allow...

“...However, predicting drug responsiveness has been challenging due to variability between patients. Lambda Biologics’ patient-derived organoids address this issue by reflecting the unique characteristics of individual patients. These organoids allow...
Experience the next level of ovarian cancer research with our hOVC organoids. Utilizing sophisticated 3D cell culture techniques, these organoids replicate the intricate microenvironment of human ovarian cancer, capturing the diverse cellular makeup of the disease.
This advanced modeling enables more accurate simulation of tumor behavior, providing a critical tool for pioneering new treatments and understanding cancer’s complex dynamics.
Step into a new realm of precision oncology with our innovative organoids.


Ovarian cancer organoid
H&E | CA125 | HE(HE4) | PAX8 | WT1 | |
|---|---|---|---|---|---|
Cancer tissue | |  |  |  |  |
Cancer organoid |  |  |  |  |  |
Our hOVC organoids are at the forefront of ovarian cancer research, precisely replicating the expression patterns of key markers such as CA125, HE4, PAX8, and WT1 found in patient tumors.
This high-fidelity modeling captures the complex pathology of ovarian cancer, enabling deeper insights into the disease mechanisms.
By accurately mimicking these molecular features, our organoids serve as a powerful tool for developing personalized therapies, promising a new era of treatment innovations that are as precise as they are effective.
Dive into the future of ovarian cancer treatment with our cutting-edge hOVC organoids and witness how we turn advanced research into life-saving solutions.
Our human ovarian cancer (hOVC) organoids provide unique insights into drug responses, enabling precision in therapeutic analysis. By differentiating how each organoid reacts to treatments, we can tailor cancer therapies to individual tumor profiles. This approach enhances the effectiveness of treatments, ensuring personalized care based on detailed, reliable data. Dive into the future of personalized medicine with our advanced hOVC organoids.

hOVC-24-009BS
Cisplatin

hOVC-24-009BS
Carboplatin

hOVC-24-009BS
Paclitaxel